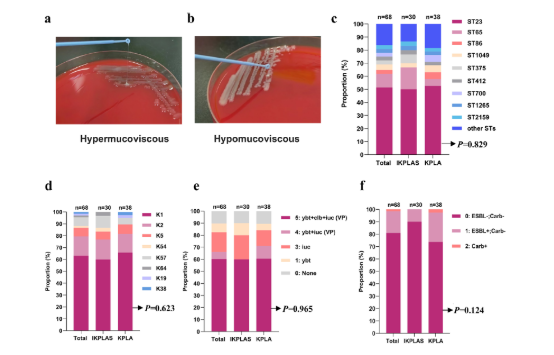
新闻图片2

14 年
手机商铺
公司新闻/正文
32 人阅读发布时间:2026-04-01 10:50
在全球范围内,侵袭性肺炎克雷伯菌肝脓肿综合征(IKPLAS)的发病率持续攀升,其高死亡率和严重并发症一直是临床治疗的棘手难题。《Nature Communications》发表重磅研究,首次揭示了乳酸通过 PTS-CRP 轴调控肺炎克雷伯菌荚膜多糖(CPS)合成、增强细菌毒力的核心机制,为 IKPLAS 的诊疗提供了全新靶点。Absin 作为实验工具支持方,其 ELISA 试剂盒在炎症因子检测中发挥了关键作用,助力科研团队精准解析宿主免疫应答机制。
文献标题:Lactate promotes invasive Klebsiella pneumoniae liver abscess syndrome by increasing capsular polysaccharide biosynthesis via the PTS-CRP axis
发表期刊:Nature Communications(IF 15.7)
DOI:10.1038/s41467-025-61379-9使用Absin产品:Mouse IL-6 ELISA Kit(abs520004)、Mouse TNF-α ELISA Kit(abs520010)、Mouse IL-1β ELISA Kit(abs520001)

以往研究多聚焦于肺炎克雷伯菌的微生物特征,但无法完全解释 IKPLAS 的发病机制。本研究创新性地将宿主因素与细菌毒力调控相结合,采用 “临床样本分析→体外机制验证→体内动物实验” 的三步走策略:
研究发现,IKPLAS 患者血乳酸水平显著高于单纯 KPLA 患者,且高于肺炎克雷伯菌引起的呼吸道感染、尿路感染患者(补充图 1)。多因素回归分析证实,血乳酸升高(OR=4.547,P=0.008)是 IKPLAS 发生的独立风险因素,而两组患者的肺炎克雷伯菌在分子特征(序列型、血清型、毒力基因等)上无显著差异(图 1),提示宿主因素在疾病进展中起主导作用。
IKPLAS 与 KPLA 组肺炎克雷伯菌分子特征对比(原文图 1)
体外实验显示,40mM 乳酸(模拟肝脓肿微环境浓度)可使肺炎克雷伯菌 CPS 合成量达到峰值,同时增强细菌的抗吞噬能力(图 3f)。分子机制上,乳酸通过下调甘露糖特异性磷酸转移酶系统(man-PTS)的 gfrA-D 基因表达,降低胞内 cAMP 水平,进而减弱 cAMP 与 CRP 的结合,最终解除对 CPS 合成的抑制(图 5-7)。
小鼠肝脓肿模型中,经乳酸处理的肺炎克雷伯菌感染后,小鼠死亡率显著升高(图 4b),肝脏等组织细菌载量增加,肝组织炎症损伤更严重(图 4c),血清中 IL-6 等炎症因子水平显著升高(图 4e),证实乳酸通过促进 CPS 合成增强细菌毒力。

乳酸增强肺炎克雷伯菌体内毒力实验结果(原文图 4)
本研究中,炎症因子的定量检测是解析宿主免疫应答的核心环节,Absin 的 ELISA 试剂盒凭借高特异性和灵敏度,为实验结果提供了可靠支撑:
RAW264.7 巨噬细胞感染肺炎克雷伯菌后,通过 Absin ELISA 试剂盒检测细胞上清中 IL-1β、IL-6、TNF-α 水平(图 3i-k),发现乳酸处理组 IL-1β 蛋白表达显著升高,而 IL-6 和 TNF-α 无明显变化,提示乳酸诱导的 CPS 合成可特异性激活 IL-1β 介导的炎症反应,为理解细菌逃逸宿主免疫的机制提供了关键数据。

巨噬细胞上清炎症因子检测结果(原文图 3 部分)
通过 Absin ELISA 试剂盒检测感染小鼠血清中炎症因子(图 4e-f),证实乳酸处理的细菌感染后,小鼠血清 IL-6、TNF-α 水平显著升高,与肝组织病理损伤程度(图 4c、g-h)一致,直接验证了乳酸增强细菌毒力的体内效应,为机制结论提供了体内证据支撑。
小鼠血清 IL-6、TNF-α 检测结果(原文图 4 部分)
本研究首次阐明了乳酸在 IKPLAS 发病中的关键作用,为临床通过调控乳酸水平干预疾病提供了新思路。而 Absin 的 ELISA 试剂盒作为免疫应答检测的核心工具,凭借稳定的性能和精准的定量结果,助力科研团队清晰勾勒出 “细菌毒力增强→宿主炎症反应失衡” 的病理链条,为机制验证提供了不可或缺的技术支持。
在感染性疾病研究中,炎症因子的动态变化是解析宿主 - 病原体互作的重要窗口。Absin 将持续深耕生命科学研究工具领域,提供更多高性价比的 ELISA 试剂盒、抗体等产品,助力科研人员在感染机制、免疫调控等领域取得更多突破性成果!
本文内容基于《Nature Communications》(DOI: 10.1038/s41467-025-61379-9)原文献;文中涉及的原文献图片、数据等知识产权归原期刊及研究团队所有。若存在侵权情形,敬请及时联系我方删除,我方将积极配合处理。